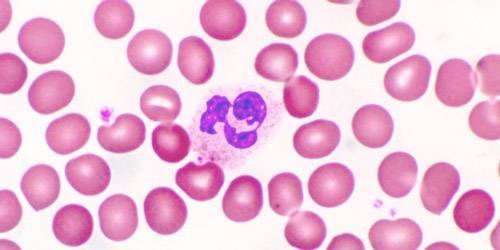
image

Эозинофилы — группа гранулоцитарных лейкоцитов. Повышение показателей называется эозинофилией, а снижение — эозинопенией. При подобных нарушениях в картине крови говорят о плохом состоянии защитных сил организма.
Эозинофилы защищают организм от аллергенов и паразитов, задействованы в противосвертывающей системе крови (предупреждают агрегацию тромбоцитов), активируют рецепторы к определенным иммуноглобулинам. Их доля среди других защитных телец невелика, однако, их роль в иммунитете существенна.
Роль и функции эозинофилов
Защитные тельца вырабатываются в костном мозге из клеток-предшественниц. Созревание занимает приблизительно 9 суток. В дальнейшем гранулоциты выходят в кровеносное русло, а через еще несколько часов — в периферические ткани. Соотношение клеток в костном мозге, крови и периферии приблизительно 3:1:3.
Клетки выжидают столкновения с чужеродным генетическим материалом. Наибольшие концентрации сосредоточены на слизистых оболочках, в органах ЖКТ, дыхательной системе. При попадании в организм чужеродных белков они выделяют ферменты, частично поглощают их, привлекают к «входным воротам» другие иммунные тельца, запуская воспалительную реакцию. Это возможно благодаря специфическим свойствам эозинофилов:
- хаотично передвигаются, всегда по направлению к патологическим очагам (хемотаксис);
- могут проникать сквозь стенки сосудов;
- повышают чувствительность рецепторов к иммуноглобулину Е (запускают аллергические реакции);
- способны как активировать, так и подавлять аллергию;
- поглощают мелкие клетки либо их частицы.
В периферической крови эозинофилы выполняют защитные функции около 2 недель, после чего сменяются новыми тельцами. Они слабо задействованы при воспалительных реакциях инфекционного генеза и более активны при вторжении паразитов или аллергенов, активном распаде тканей (например, при злокачественных опухолях).
Нормы показателей
Численность эозинофилов в периферической крови измеряют при общем ее анализе (ОАК) с лейкограммой. Обычное исследование подразумевает подсчет только общего числа лейкоцитов (без разделения на группы). Нормы одинаковы для взрослых людей обоих полов. В протоколе указывают процентное содержание клеток, а также абсолютное — количество телец в единице объема биоматериала (мкл, л). Лаборатории могут использовать различные единицы измерения, что нужно учитывать при чтении результата.
Таблица — Референтные значения в лейкоцитарной формуле
| Группа клеток | Доля, % | Абсолютный показатель, 10⁹/л |
| Палочкоядерные нейтрофилы | 1‒6 | 0,04‒0,3 |
| Сегментоядерные | 48‒75 | 2,0‒5,5 |
| Эозинофилы | 0,5‒5 | 0,02‒0,3 |
| Базофилы | 0‒1 | 0,0‒0,065 |
| Лимфоциты | 19‒37 | 1,2‒3,0 |
| Моноциты | 3‒11 | 0,09‒0,6 |
Уровень клеток изменяется на протяжении суток под действием гормона кортизола (гормон стресса). Минимальные значения определяются ранним утром, поэтому ОАК нужно сдавать вскоре после пробуждения и обязательно натощак. Доля эозинофилов может несколько изменяться у пациентов разного возраста. Более высокие показатели свойственны детям старше года (до 0,7*10⁹/л) и допускаются в возрасте около 5 лет, что сопряжено с очередным «перекрестом» и становлением иммунитета. Значения в % изменяются несущественно.
Таблица — Нормальный процент эозинофилов у детей
| Возраст | Доля, % |
| До 2 недель | 1‒6% |
| До года | 1‒5% |
| До 2 | 1‒7% |
| До 5 | 1‒6% |
| До 6 | 1‒5% |
О чем говорят пониженные эозинофилы
Количество обсуждаемых клеток в крови и без того небольшое. Критическим снижением считается их полное отсутствие, содержание менее 50 клеток в 1 мл биоматериала, или доля среди других иммунных телец ниже 0,5%. Состояние называют эозинопенией. Это лабораторный термин, который не может быть самостоятельным диагнозом. Отклонения сопровождают некоторые состояния, чаще всего сопряженные с угнетением функций костного мозга и замедлением синтеза телец. Причинами могут быть:
- Инфекционные заболевания. Эозинопению вызывают тяжелые заражения организма, при которых значительно ослабевает иммунитет либо костный мозг истощается (идет перерасход защитных клеток). Такое возможно при брюшном тифе, дифтерии, пневмонии, перитоните. Чаще всего угнетение кроветворения наблюдается на фоне сепсиса. На начальных этапах проявляется повышением уровня нейтрофилов. При гнойных процессах уровень сегментоядерных клеток снижается.
- Поражение внутренних органов. Снижение концентрации эозинофилов возможно при воспалительных или некротических повреждениях внутренних органов. В таком случае происходит перераспределение телец, что отражается на картине периферической крови. Подобное наблюдается при обострении желчнокаменной болезни, холецистите, панкреатите. Выраженная эозинопения всегда возникает в первые сутки после инфаркта миокарда,
- Интоксикации. Угнетение функций костного мозга провоцируют соли тяжелых металлов. Отравления ими, как правило, сопровождаются полиорганной недостаточностью. Возможна интоксикация соединениями ртути, свинца, таллия, висмута или мышьяком.
- Недостаточность костного мозга. Синтез лейкоцитов страдает при злокачественных опухолях, метастазах, раке крови и лимфатической системы.
- Шоковые состояния. Они могут быть инфекционного или травматического генеза. Уровень клеток всегда падает после значительных травм, обширных ожогов. Анафилактический шок сопровождается повышением базофилов. При болевом шоке снижаются эозинофилы и лимфоциты, нередко обнаруживается, что все лейкоциты понижены.
- Лечение. Функции костного мозга подавляют гормональные средства, цитостатики и другие препараты, использующиеся при химиотерапии. Радиация и облучение, применяющиеся при лечении онкопатологий, также вызывают эозинопению.
- Эндокринные заболевания. Нарушения показателей эозинофилов чаще всего наблюдаются при дисфункции работы надпочечников и щитовидной железы. Почти полное отсутствие клеток сопутствует гиперкортицизму (чрезмерно активной выработке гормонов надпочечников).
- Перенапряжение. Стрессовые ситуации и повышенные физические или умственные нагрузки сначала провоцируют мобилизацию иммунных сил. Несколько позже гемопоэз истощается, а уровень всех лейкоцитов снижается. Такое возможно после сильных потрясений, депрессии, при хроническом стрессе, чрезмерных физических нагрузках, хроническом недосыпании, алиментарном истощении (недоедании).
Развитие эозинопении характерно для синдрома Гудпасчера (поражение легких, чаще встречается у мужчин до 30 лет), диссеминированного туберкулеза, экземы Капоши, внезапной экзантемы (особых высыпаний), нервно-артритического диатеза и даже синдрома Дауна. Механизм снижения уровня защитных телец не установлен.
Причины у детей
Нехватка эозинофилов наблюдается у недоношенных новорожденных с инфекционными заболеваниями. До 12 лет возможна переходящая эозинопения, которая при отсутствии тревожных симптомов считается вариантом нормы. Снижение доли эозинофилов может происходить за счет роста других защитных телец. Например, вначале воспалительных заболеваний повышается СОЭ и процент моноцитов. Такое возможно при простуде, ОРВИ, гриппе, бактериальных инфекциях. В последнем случае снижение показателя эозинофилов сопряжено с повышением лимфоцитов.
Причины при беременности
Отклонения уровня лейкоцитов у будущих мам не считается признаком патологии. В начале беременности это результат действия гормонов и развития физиологического иммунодефицита, направленного на сохранение плода в утробе матери и профилактику его отторжения иммунитетом. Как правило, во втором триместре все показатели нормализуются.
Сохраняющаяся эозинопения не привлекает внимания врача при условии соответствия всех остальных параметров клинического анализа крови норме. На поздних сроках мамы сталкиваются с малокровием. На фоне В12-дефицитной анемии также возможно угнетение синтеза эозинофилов. При этом падают значения гемоглобина и эритроцитов.
Эозинопения часто возникает в послеродовый период (что связано с физическим напряжением, психоэмоциональным, травмами). Показатели приходят в норму через 2 недели.
Как устранить нарушение
С неудовлетворительными результатами ОАК следует обращаться к терапевту, ребенка нужно показать педиатру. Опрос и осмотр пациента направлен на выявление возможных причин отклонений. Скорее всего, врач посоветует сдать тест повторно, через 5-7 дней. К исследованию нужно правильно подготовиться, чтобы исключить ложные результаты. Если нарушения будут обнаружены повторно, нужно начинать обследование. Оно может включать:
- биохимию крови;
- анализ мочи;
- печеночные пробы;
- онкомаркеры;
- генетические тесты;
- УЗИ внутренних органов;
- в редких случаях биопсию костного мозга, лимфатических узлов.
При необходимости терапевт даст направление к узкопрофильному специалисту. Лечение полностью зависит от провоцирующего фактора. При острых инфекциях назначают антибиотики, при осложненных заболеваниях, шоке, интоксикациях пациента госпитализируют. Эозинопению, вызванную стрессами или истощением, лечат с помощью психотерапии, витаминных и седативных препаратов. Если обнаружится взаимосвязь нарушений с приемом медикаментов, потребуется замена лекарств или коррекция дозы.
Часто задаваемые вопросы
Вопрос: Можно ли избавиться от эозинопении с помощью трав? Если да, то каких?
Ответ: Лечить нужно не само отклонение в ОАК, а его причины. Не факт, что проблема вызвана угнетенным состоянием иммунитета. Самолечением лучше не заниматься. Есть риск пропустить опасное заболевание и даже усугубить его течение. Если человек знает наверняка, что нарушения вызваны стрессовыми ситуациями или дефицитом питательных веществ в рационе, высокими нагрузками, есть смысл прибегнуть к общеукрепляющим мерам. Нормализовать работу защитных сил помогают рациональное питание, умеренные физические нагрузки, закаливание, частые пешие прогулки. Когда очень хочется прибегнуть к фитотерапии, можно воспользоваться травами с адаптогенными свойствами. К таковым относят эхинацею пурпурную, родиолу розовую, элеутерококк и женьшень. Их экстракты можно приобрести в аптеке в готовом виде.
Вопрос: Как подготовиться к анализу, чтобы исключить ложноположительный результат? Сдаю ОАК в 3 раз, в предыдущие 2 врач засомневался, что результат правильный.
Вопрос: Можно ли сдавать ОАК во время месячных? Как они могут повлиять на показатели?
Ответ: Сдавать анализ во время менструации без особой необходимости не стоит. В этот период любой из показателей может выйти за пределы нормы, что не связано с заболеванием. Врачи рекомендуют воздержаться от любых лабораторных тестов за 3 дня до, непосредственно во время кровотечения и 2‒3 дня после. Однако относительно эозинофилов есть другая версия. Считается, что значение этих кровяных телец может снижать прогестерон. Если сомнения вызывают именно эозинофилы, стоит сдать анализ после месячных, однако до овуляции (7‒13 день цикла).
Вопрос: Можно ли понизить уровень эозинофилов препаратами, использующимися при аллергии до критических значений?
Ответ: Антигистаминные средства мало влияют на картину крови, если использовать их правильно и соблюдать рекомендованные дозы. Важно соблюдать продолжительность курса, вовремя делать перерывы или менять медикаменты. Существенные отклонения в картине крови способны вызвать гормональные средства, поэтому с ними нужно соблюдать осторожность и применять только по назначению врача.
Вопрос: Помогут ли растительные средства из группы иммуностимуляторов (например, Иммунал или Иммупрет) повысить уровень эозинофилов?
Ответ: Помогут, если отклонение вызвано перенесенным инфекционным заболеванием, истощением организма, стрессами. Если природа нарушений заключается в гнойных процессах, злокачественных или наследственных патологиях, стимуляторы иммунитета не помогут, а при заболеваниях костного мозга или желез внутренней секреции могут даже навредить.
Выводы
Количество эозинофилов в крови в норме небольшое. Критическим снижением считается их полное отсутствие или содержание менее 50 клеток в 1 мл биоматериала (в этом случае доля среди других иммунных телец ниже 0,5%). Это только лабораторное значение, которое не может быть диагнозом. Состояние может быть вызвано:
- эндокринными нарушениями;
- инфекционными заболеваниями;
- поражениями костного мозга;
- лекарственными препаратами;
- хроническим стрессом.
Если при ОАК выявлено малое количество эозинофилов в крови, следует пересдать тест. При повторном обнаружении отклонений нужно обратиться к доктору. Лечить нужно не эозинопению, а состояние, которое к ней привело, что возможно только после полноценной диагностики.
Повышается количество эозинофилов во время аллергических реакций или заражения паразитами, а также при некоторых опухолевых заболеваниях. Все это опасно для здоровья. Подробнее читайте в статье «Эозинофилы повышены в анализе крови: о чем это говорит, лечение».
Что такое эозинофилы и какие функции в организме человека они выполняют
Эозинофильные кровяные тельца являются подвидом лейкоцитов, а именно — гранулоцитов. Лейкоциты в целом выполняют функцию защиты организма от внутренних и внешних инородных патогенных агентов. В крови эозинофилы, как и все другие лейкоцитарные тельца, не имеют собственной окраски. Свое название они получили как раз благодаря тому, что в отличие от остальных лейкоцитов окрашиваются только с помощью эозина — специального кислого красителя.
Еще одним важным отличием этой разновидности лейкоцитов является то, что они представляют собой микрофаги, то есть способны уничтожать только микроскопические инородные тела и клетки. Однако главная функция эозинофилов состоит не в этом. Их важнейшим заданием является противодействие паразитарным заражениям. При появлении в организме воспалительного процесса эозинофилы проникают в его очаг и способствуют активации клеточных рецепторов, отвечающих за естественную противопаразитарную защиту.
Эта защита состоит в том, что клетки, находящиеся ближе всего к паразитирующему микроорганизму, саморазрушаются и заключают патогенный агент в своеобразный кокон, не дающий вредоносным клеткам развиваться. После создания такого барьера в организме активизируются другие иммунологические механизмы, которые уже действуют направленно на выявленную опасность. Таким образом, эозинофилы как бы формируют реакцию организма на внутренние и внешние раздражители. Эта реакция может быть слишком активна, приводя к аллергии. А может, наоборот, притупляться, реагируя на разные факторы. Если эозинофилы ниже нормы, то такая ситуация называется эозинопенией. Какие факторы ее вызывают?
Из-за чего возникает эозинопения и нужно ли ее лечить
Нормальный уровень данного вида лейкоцитов в крови определяется у взрослого человека на уровне от 1 до 5%. У детей процентное количество эозинофилов в крови больше, но постепенно снижается и достигает нормальных показателей к возрасту 13-15 лет. Поэтому в подростковом возрасте могут проходить многие регулярные аллергии, мучившие ребенка раньше. Однако что означает, если эозинофилы понижены? Чаще всего ключевыми факторами, приводящими к возникновению эозинопении, являются:
- протекание острой бактериальной инфекции;
- наличие острого аппендицита, перитонита, сепсиса и т.д.;
- перенесенное оперативное вмешательство, приводящее к высокому уровню травмирования разных тканей;
- сильные телесные повреждения, травмы, переломы, ожоги;
- отравления, токсический шок;
- интенсивное физическое переутомление, особенно имеющее регулярный характер;
- сильное одноразовое психическое расстройство или постоянное стрессовое воздействие на психику;
- регулярное недосыпание, вызванное самыми разными причинами.
Таким образом, причины того, что анализы показывают пониженные эозинофилы в крови, могут быть самыми разнообразными. Поэтому, получив результат, показывающий низкий уровень эозинофилов, не следует расстраиваться. Важно понять, что это значит, и найти более менее рациональное объяснение выявленному уровню этого вида лейкоцитов.
Если человек болен острым инфекционным заболеванием или находится на стадии излечения от него, то низкий процентный показатель эозинофилов может быть попросту обусловлен резким повышением в крови нейтрофилов, необходимых для борьбы с патогенными инфекционными агентами. Абсолютное же количество эозинофилов может при этом оставаться в норме, тогда как анализ покажет их относительное снижение.
В целом при инфекциях не стоит панически относиться к снижению данного показателя.
Кроме перечисленных выше причин, понизить уровень эозинофилов может также прием некоторых лекарственных препаратов. Поэтому, если врач ищет причину данного отклонения в анализе крови, ему обязательно нужно перечислить, какие медикаменты принимались пациентом в течение последних двух недель. К тому же пониженный уровень данного вида лейкоцитов может быть обусловлен перенесенными недавно родами. Что же делать, если проведенный анализ крови показал значительно пониженный уровень эозинофилов?
Следует ли лечить эозинопению
Сама по себе эозинопения не является болезненным состоянием. Она не должна восприниматься как опасный диагноз и рассматриваться в качестве болезни, относительно которой следует принимать непосредственные терапевтические мероприятия. Пониженный процентный показатель эозинофилов важен, потому что он может свидетельствовать о возникновении какого-либо заболевания. Чаще всего это заболевание (например острая бактериальная инфекция) уже выявлено и лечится, поэтому на данный пункт из анализа крови врач может вообще не обратить особого внимания. Этому не стоит удивляться.
Если же перед проведением анализов человек не болел, не травмировался, не переносил оперативные вмешательства или острые стрессовые состояния, то понижение процентного уровня эозинофилов может стать важным симптомом. В таком случае врач должен комплексно рассмотреть результаты анализов, чтобы выявить другие отклонения, указывающие на то или иное заболевание. Если таковых нет, и пациент чувствует себя нормально, то нужно просто подождать. Эозинофилы вполне могут прийти в норму.
Такая ситуация случается, например, после какого-то излишнего физического перенапряжения. Человек, не привыкший активно двигаться, пробежался за отъезжающим автобусом или взошел по ступенькам на пятый этаж поликлиники. Это для него стало значительным, хоть и временным физическим потрясением. После этого он сдал анализы, а про свои случайные «приключения» и думать забыл. Не вспомнит он о них и тогда, когда врач будет искать причину понижения уровня эозинофилов.
Однако чаще всего данный показатель свидетельствует о возможном наличии серьезных проблем. Особенно важно обратить на него внимание людям, регулярно переживающим стрессовые состояния. Такие результаты анализов могут свидетельствовать о том, что психические потрясения уже глубоко влияют на физическое состояние организма. В этой ситуации необходимо обратиться к врачу.
Нормальная концентрация эозинофилов в крови
В медицинской практике различают два значения общей численности. Общий объем, характеризует общее количество эозинофильных клеток. Коэффициенты относительного уровня выражают количественный состав эозинофилов в соотношении к лейкоцитам.
Нормальные показатели в женском и мужском организме практически совпадают, но зачастую колеблются с возрастными категориями. Абсолютные показатели не так важны для постановки диагноза, как лейкоцитарная формула.
Низкий уровень эозинофилов в крови
Процесс выработки защитных клеток – эозинофилов, происходит в красном костном мозге из недифференцированных клеток. Закончив формирование, они двигаются в кровь на несколько суток, которых хватает для полного уничтожения, обнаружения чужеродных патогенов. Выполнив непосредственную работу, в русле, эозинофилы транспортируются во все тканевые структуры внутренних органов, начиная там работать. Высокий процент этих представителей лейкоцитов содержится в органах, которые контактируют с внешними раздражителями (легкие, кожа, система пищеварения, носоглоточное пространство).
В пределах нормы количество эозинофилов в плазме крови составляет от 1–5% общей численности лейкоцитов, и значительно зависит от времени суток.
Уровень концентрации в детском организме эозинофилов в крови понижается, как и у взрослого человека, составляя около 1%. Но верхняя черта сильно увеличивается, если ребенок старше. У взрослого человека и ребенка пониженные эозинофилы диагностируют, учитывая низкий уровень показателя 0,5%.
Эозинопенией(значимым снижением количества эозинофилов) считается снижение их абсолютного числа менее 200 в микролитре.